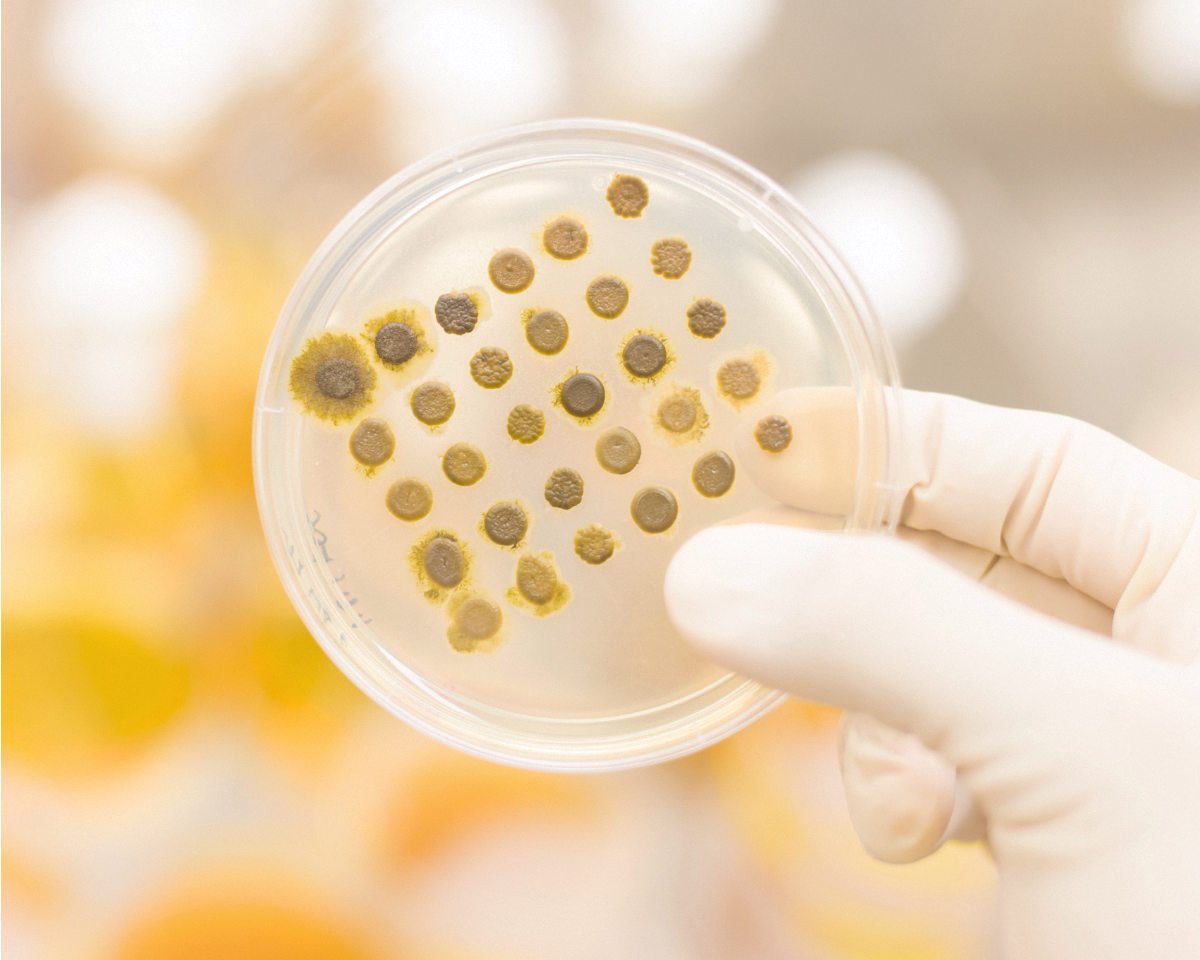

Why Do London Homes Need Professional Mould Removal and Remediation Services?
London’s housing creates near-perfect conditions for mould. Victorian terraces, converted period flats, single-glazed windows, and over 160 wet days a year push average winter humidity above 80%. Condensation settles, moisture builds, and mould follows quickly. London Mould Pros offers mould removal, mould remediation, mould inspection, mould testing, and water damage restoration across the city, delivered by IICRC certified technicians with seven years of London experience behind them.

London's Trusted Mould Removal Specialists
London Mould Pros has been treating mould in London properties for over seven years. In that time, we’ve worked in more than 2,500 homes across the city, from basement flats in Islington to loft conversions in Greenwich. Every technician on our team holds full IICRC certification, the recognised professional standard for mould remediation in the UK.
We’re available 24 hours a day, seven days a week, because mould emergencies don’t wait for business hours. We offer a satisfaction guarantee on all remediation work, and we deal directly with insurers when the damage is covered. London homeowners choose us over other mould removal companies because we tell the truth, do the job properly, and back it up. Give us a ring.
Serving London & Surrounding Areas
We cover all of Greater London, with a strong presence in the boroughs we’ve served since day one. Whether you’re in a basement flat in Hackney or a Victorian semi in Greenwich, we know the area, we know the housing stock, and we’re not far away.
We service all of greater London and beyond. Not sure if we cover your area? Give us a ring and we’ll confirm straight away.
Is Your Home Showing These Warning Signs?
– Discoloration on walls or ceilings
– Yellow, brown, or copper stains
– Peeling or bubbling paint
– Warped or buckled surfaces
– Persistent earthy or damp smell
– Odor stronger in certain rooms
– Smell worsens with humidity
– Can’t locate the source
– Persistent coughing or sneezing
– Itchy eyes or throat irritation
– Respiratory issues or asthma
– Symptoms worse indoors
– Black, green, or white spots
– Fuzzy or slimy texture
– Growth in corners or damp areas
– Spreading pattern visible
What Causes Mould Growth in London Homes?
London gets around 160 rainy days a year, and winter humidity regularly sits above 80%. That’s not unusual for a British city, but what makes London particular is the housing. A large proportion of the city’s homes are Victorian or Edwardian, built before cavity wall insulation existed and often never retrofitted. Cold external walls, minimal loft insulation, and single-glazed sash windows create the temperature differential that causes condensation on surfaces overnight.
For small patches of surface condensation in a well-ventilated bathroom, a good clean and a dehumidifier may be enough. But if mould keeps returning, spreads to another room, has a smell you can’t shift, or appears on a wall that shouldn’t be damp, that’s when mould removal services and a proper inspection are the right call. Treating the surface doesn’t fix the cause.
When Does Mould Removal Become an Emergency?
A mould emergency isn’t just a particularly bad patch behind the bathroom cabinet. It’s when the situation has moved beyond what a standard scheduled job can safely manage.
If you’ve had a burst pipe, a flood, or significant roof water ingress, mould can take hold within 48 hours. That’s not an exaggeration. Given warmth and moisture, certain mould species can double in coverage in two days. By the time you’ve had a tradesperson in to fix the pipe and arranged a mould inspection for the following week, you may be looking at a significantly larger job.
When someone rings us at 11pm because they’ve just found black growth spreading behind the kitchen units after a slow leak, we don’t tell them to call back Monday. We get there, thermal camera and HEPA scrubbers ready, assess the full extent with moisture metres, and contain it before it spreads further. Speed matters with mould. Every day counts.

How it Works — Simple and Fast
Contact Us
Inspection
Remediation

Our Professional Mould Remediation Process Explained
When we arrive, the first thing we do is a full inspection: thermal imaging cameras to find cold spots where condensation forms, industrial moisture metres to map the extent of damp through walls and floors, and a visual check of likely mould routes. You get a clear picture of what’s happening before we touch anything.
Then containment. Barrier sheeting goes up around the affected area and we run negative air pressure machines so spores can’t drift to clean parts of the property while we work. This is where professional mould removal genuinely differs from a DIY effort.
We remove contaminated material where necessary, treat all affected surfaces with IICRC-approved antimicrobial solutions, and dry everything down with industrial drying equipment. Then we run air quality testing to confirm spore counts are back to safe levels before we sign off.
Professional Mould Testing and Air Quality Analysis
There’s a practical difference between a mould inspection and mould testing, and it’s worth knowing which one you actually need.
A mould inspection is a visual and instrument-based assessment: our technician looks, uses a thermal camera and moisture metre, and gives you a clear picture of where mould is, how far it’s spread, and what’s causing it. For most jobs, this is enough to proceed confidently with remediation.
Mould testing goes further. Air sampling involves drawing measured volumes of air through a cassette, which then goes to a laboratory to be counted for spore types and concentrations. Surface swabs are taken from specific areas and cultured in a lab to identify the exact species present. This matters when you need documentation for a landlord dispute, an insurance claim, or a health concern that requires a professional diagnosis.
Common Mould Types Found in London Homes
Not all mould is the same, and knowing which type you’re dealing with matters for treatment. London’s damp, cool winters favour particular species. We identify mould accurately on-site using visual assessment and, where needed, laboratory testing, so you know exactly what you’re up against.
Frequently Asked Questions
We’ve pulled together the questions we hear most often from London homeowners and tenants. If your situation is specific, ring us on 07700 900456 and we’ll talk you through it directly, no obligation, no sales pitch.
What is mould remediation and how does it work?
Mould remediation is the complete process of eliminating mould and preventing regrowth—it’s more than just removal. We identify moisture sources, contain affected areas to prevent spore spread, remove contaminated materials, treat surfaces with antimicrobial solutions, dry everything completely, and conduct air quality testing. Removal just cleans visible mould. Remediation fixes the underlying problem, addresses hidden growth, and creates conditions where mould can’t return. That’s why we use the term remediation.
How much does mould removal cost in London?
Costs in London depend on the size of the job, the type of mould, the surfaces involved, and whether post-treatment air quality testing is needed. Small jobs, like a bathroom ceiling or a single affected wall, typically run between £300 and £600. Larger remediation projects involving multiple rooms or significant water damage can reach £1,000 to £3,000 or more. The best way to get an accurate figure is to book a free inspection, which we offer with no obligation. We quote itemised and clearly before any work starts.
How long does mould remediation take?
A small to medium job, covering one room or a contained area, usually takes between half a day and a full working day. Larger projects, where multiple rooms are affected or there’s structural drying involved, can run over two to three days. What extends the timeline most is drying time, which we can’t rush safely. We’re upfront about realistic timelines at the inspection stage. We work tidily, contain the area properly, and aim to keep disruption as low as possible throughout.
Is mould removal covered by insurance?
It can be. Most home insurance policies cover mould damage that results from a sudden, insured event, such as a burst pipe, storm damage, or a flooding incident. What they typically don’t cover is mould that’s developed gradually through long-term condensation or neglect. If your mould problem is linked to an insured event, it’s worth making a claim. We work directly with insurers and can provide the documentation they need. Check your specific policy wording, and ring us if you’re unsure.
What's the difference between mould removal and mould remediation?
Removal means cleaning visible mould off surfaces. Remediation addresses the entire problem—finding moisture sources, removing contaminated materials, treating affected areas, fixing conditions that allowed growth, and preventing recurrence. IICRC standards require full remediation, not just surface removal. Anyone can spray bleach on bathroom mould. Professional remediation eliminates hidden growth behind walls, identifies why it’s growing, and implements solutions so it doesn’t return. We perform remediation because removal alone doesn’t solve the problem.
Do you offer 24/7 emergency mould removal in London?
Yes. We’re available around the clock, every day of the year. If you’ve had a flood, a burst pipe, or you’ve discovered significant mould growth that’s getting worse quickly, don’t wait until morning. Ring 07700 900456 and we respond immediately. We’ll ask a few questions to assess urgency, get a technician to you as quickly as possible, and arrive with containment barriers and HEPA equipment ready to go. Health symptoms worsening, large affected areas, or post-flood situations all qualify as emergencies.
What certifications do your technicians have?
Every London Mould Pros technician holds IICRC certification, which is the Institute of Inspection Cleaning and Restoration Certification, the internationally recognised professional standard for mould remediation and water damage restoration. IICRC certification means our technicians have been trained and assessed on industry-approved processes, containment standards, and safe removal techniques. We’re also fully licensed and insured. These aren’t just credentials on a wall. They represent genuine training in a process that protects both the property and the people living in it. When you’re choosing a mould removal company, qualifications matter.

Ready to Eliminate Your Mold Problem?
Talk to a Certified Expert Now








